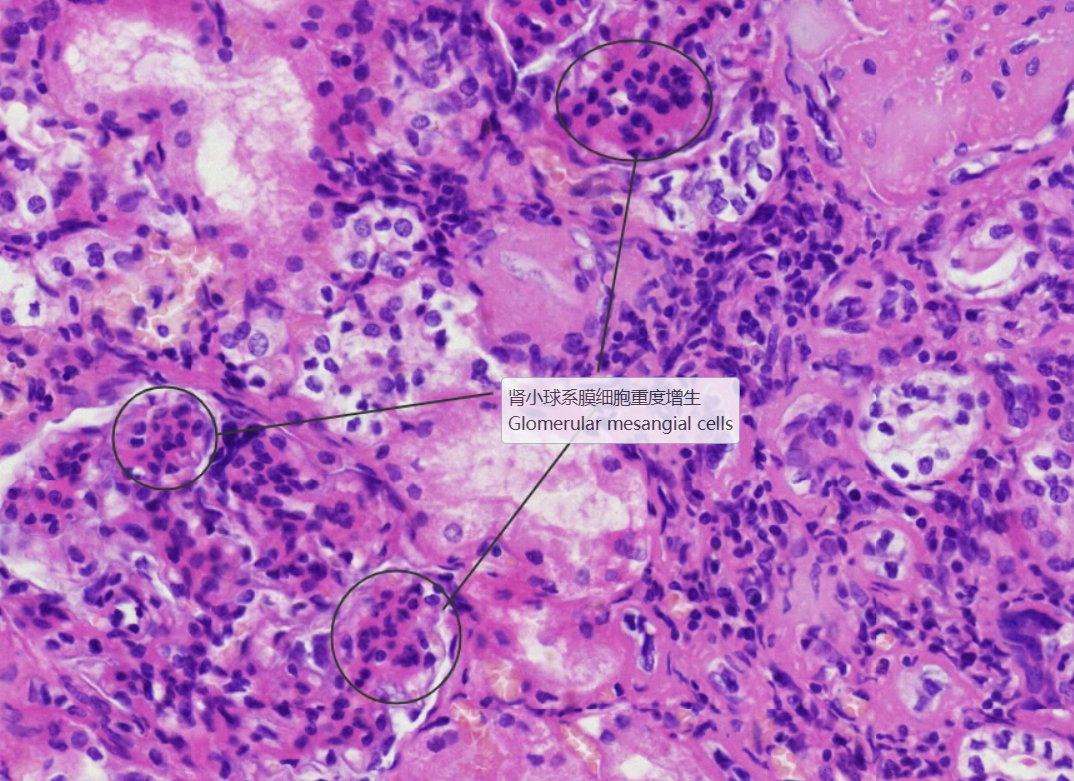

正常-病理对照图
-
1 肾脏
-
2 系膜增生性肾炎
-
3 慢性硬化性肾小球肾炎
上一节
下一节
低倍镜:分辨被膜、皮质和髓质。高倍镜:(1)肾小体,由血管球和肾小囊组成。肾小囊壁层为单层扁平上皮,脏层为足细胞包在血管球的表面,在切片上不容易分出。两层上皮之间为肾小囊腔。(2)近曲小管在肾小体的周围,管腔小凹凸不平不规则,管壁厚,上皮细胞较大,分界不清,核圆,位于近基底部,胞质强嗜酸性,呈深红色,游离面有刷状缘。(3)远曲小管也在肾小体的周围,与近曲小管相比,官腔相对较大而规则,上皮细胞较小,分界较清楚,核圆,位于中央或近腔面,胞质弱嗜酸性,呈浅红色,游离面无刷状缘。(4)细段在近肾乳头部易找到。细端管腔小,管壁为单层扁平上皮,但比毛细血管内皮稍厚。(5)致密斑为远曲小管靠近肾小体侧的上皮细胞形成的椭圆形斑。该上皮细胞呈高柱状,胞质色浅,核椭圆排列紧密。
全景图

 2.肾小体
2.肾小体


 3.近曲小管
3.近曲小管
 4.远曲小管
4.远曲小管
 5.细段、集合管
5.细段、集合管


 2.肾小球系膜细胞重度增生
2.肾小球系膜细胞重度增生 3.肾小球硬化
3.肾小球硬化 4.间质血管扩张充血
4.间质血管扩张充血

 4.肾小球代偿肥大
4.肾小球代偿肥大 5.炎症细胞浸润、纤维增生
5.炎症细胞浸润、纤维增生

